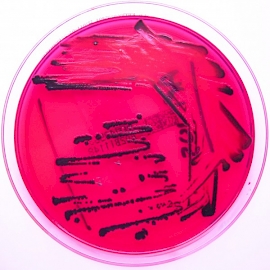

The Trans Pacific Partnership: Trade and Globalisation
Shrouded in secrecy, and acting outside established international channels for trade negotiation, will the Trans Pacific Partnership further marginalise smaller and less developed nations in their quest to secure a place in the global marketplace?
22 June 2015
Explaining the Capitalist Crisis
Following a period of relative prosperity, the survival of liberal democratic capitalism is threatened by the prolonged economic slump that set in after the 2008 banking crisis. It turns out that the case for a free market system is undermined by commonly observed scale economies; producing uneven development and inequality.
22 June 2015
The Statistical Laws behind Cities
The intersection of two unexpected fields, physics and urban studies, suggests that what defines humanity is hidden in abstract mathematical probability distributions that we use to describe cities.
22 June 2015
Power to the People: Building local energy capacity
The challenge of moving towards a low carbon future is one now embraced by the political leaders of the G7, but how that path will unfold is still a live political debate. Local energy co-operatives offer a viable and progressive path to sustainability.
22 June 2015
The Gathering Storm
A rights-based approach to protecting victims of climate-induced displacement is needed; one which recognises entitlement to assistance and protection, and leverages opportunities for safe and dignified migration.
15 May 2015
Investing in institutional ‘software’
Building resilience to extreme weather needs a systems approach, including institutional ‘software’ as well as technical, financial, and physical infrastructure – or ‘hardware’.
12 May 2015
Medical Tourism in the Tropics
Countries such as Barbados are facing legal and ethical obstacles to develop effective regulatory mechanisms for the emerging medical tourism sector.
20 April 2015
Catastrophe models could transform disaster resilience
Catastrophe models are an emerging tool for governments, NGOs and international aid agencies to assess and prepare for the risks posed by natural disasters.
9 April 2015
Ebola: 38 years, 25 outbreaks
While forming a key component of the recent Ebola response, much debate surrounds how clinical trials testing new experimental treatments for the disease should be designed.
26 March 2015
Advancing Health Research Through Online Social Networking
The recent explosion of internet-based communication and education tools has enabled medical practitioners and researchers to interact with patients in new and innovative ways.
1 June 2014
Engaging Digital Citizens for Children’s Rights
Never before has there been such a rich opportunity to engage the world’s digital citizens, including a newly empowered youth, in issues surrounding children’s rights and well-being.
1 June 2014
Smart Transport
Advancements in sensing and information technology for road transport performance measurement, such as wireless sensors and Automatic Vehicle Identification AVI, have recently begun to contribute to sustainable development and management of urban transport systems.
1 June 2014
Donated Drugs Against Neglected Tropical Diseases
One in six of the world’s population live in rural areas, and suffer from poor health - especially chronic diseases caused by infection with parasitic diseases now known as ‘Neglected Tropical Diseases’ or NTDs.
1 June 2014
The Virtual Drive
Augmented Reality (AR) has significant economic potential because it embeds virtual objects into physical reality at negligible marginal costs, while maintaining targeted advertising capabilities similar to those of the internet.
1 June 2014
Identity: Who Do You Think You Are?
By 2020, it is predicted that networked devices, streaming information and connecting us globally, will exceed 50 billion. But will we be able to switch off, or maintain distinct identities in online and offline worlds?
1 June 2014
Mobile Health: Patient, heal thyself
As mobile health technologies become prevalent there is a need to make sure they are effective and safe, but also to understand the implications for individuals and communities.
1 June 2014
From London to the Arctic
Technology can play a role in helping people to collaborate – and increasingly participate – in research experiements previously inaccessible to the non-expert.
1 June 2014
Improving the Immunogenicity of Vaccines
For maternal infections such as group B streptococcus and early infant infections such as respiratory syncytial virus infection, there is now hope for the development of successful vaccines, some based on adjuvants which are designed to boost weak immune response.
1 June 2014
How Much Surveillance Can Democracy Withstand?
We need to reduce the level of general surveillance, but how far? Where exactly is the maximum tolerable level of surveillance, which we must ensure is not exceeded?
1 June 2014
Space Biomedicine
With many distinctive technical challenges to be overcome, the spaceflight paradigm allows numerous psychological and behavioural aspects, as well as biological and physical systems to be examined under unique and unusual circumstances.
1 October 2013
Liquid Democracy: New Politics in a Connected World
What forms the basis of an emerging form of technological movement, such as that seen in Egypt and Brazil, and how might it be used to bring about a new political revolution?
1 October 2013
International Cooperation and Competition in Space
International collaboration in space exploration has provided a platform for immense technological innovation and research that has benefited a range of scientific disciplines.
1 October 2013
Astrobiology: Searching for Life in Space
The human mind is fascinated by the possibility of other life in the universe. From as early as the fifth century B.C, science fiction and science fact have been intricately linked driving forward innovation and imagination.
1 October 2013
Assistive Technology and Audiovisual Translation
Online tools such as Audiovisual Translation (AVT) and Assistive Technology (AST) have the potential to aid the provision of university-level educational material for people with sensory impairments such as blindness and deafness.
1 October 2013
Biotech and Big Pharma
From improving the process of food production to keeping up with the demands of a rising population, to developing novel and sophisticated biological treatments for life-threatening diseases, biotech can and does impact multiple aspects of our life.
1 October 2013
Digital Platforms and E-Bureaucracy in Participative Democracy
In times of widespread access to high speed internet and social media, one would expect that it is easy to reach out to millions of people and encourage them to participate in direct democracy – but experience so far has proven the contrary.
1 October 2013
Space Stations
In the near future space stations will not only orbit Earth, but other close planetary bodies such as the moon. These inter-planetary ports will not only be a station for transient passengers, but permanently host communities of both scientists and the support staff such as nurses, barbers and chefs.
1 October 2013
Metabonomics: The Future for Clinical Treatment?
Metabonomics, namely the observation of small molecules within a biological sample, has emerged as a new potential treatment due to the complexity of mainstream genetic and biomedical research.
1 October 2013
Curiosity Seeks Clues to Past Life on Mars
Well over 3.5 billion years ago when liquid water was present on Mars, it may have harboured primitive microbial-like life. If humans are ever to travel to Mars, the availability of resources will play a crucial part in the planning of such missions.
1 October 2013
Hope for Humanitarianism
Can humanitarian aid ever really be non-political? How far should NGOs go to avoid being drawn into the power-struggles inherent to warfare? And what happens when international organisations are denied access, and local communities become the only humanitarian actors?
1 October 2013
Imperialism 2.0: Do We Really Want to Save the Poor?
For the last half-century, we have heard that a shift of 1-2% of GDP from the developed to the developing world would lift as many as 1.5 billion out of poverty, yet many argue that this figure ignores ‘transaction costs’ – that is, the costs of providing the background conditions that would allow such a transfer of income to work the desired magic
1 October 2013
A WMD Free Zone in the Middle East
Nuclear proliferation in the Middle East is high on the regional and international agenda. Fear of a nuclear arms race in the region driven by tensions between Iran and Israel, and continued mistrust surrounding the Iranian nuclear programme, threaten preparations for the upcoming Helsinki conference.
1 October 2013
A Revolution in Space Propulsion
A revolution in the way we conduct deep space exploration may soon be upon us thanks to recent advances in lightweight materials, small, inexpensive satellites and a renewed willingness by policy-makers to consider new technologies and approaches.
1 October 2013
Synthetic Biology: From DNA to Dolly and Beyond
Extensive future applications surrounding this diverse subject have earned it a strong reputation amongst scientists, and led to it being deemed a ‘top research priority’ by the UK government. Whilst previous centuries evolved around the harnessing of fossil fuels, and the resulting agricultural and industrial revolutions, the 21st Century has been witness to a biological revolution.
1 October 2013
Alzheimer’s Disease
Stress caused in a particular cell organelle, the endoplasmic reticulum (ER), plays a role in Alzheimer's Disease brain cells, and has emerged as a potential therapeutic target.
1 May 2013
The Female Economy in China and India
Increasingly affluent and powerful female consumers in China and India are expected stimulate extraordinary growth – and deliver growth to the companies that serve them.
1 May 2013
The Quest for a Better Bionic Hand
The hand is a crucial part of the body, and the desire to replace it following an amputation – with trauma or cancer being the main underlying causes – is a natural one. Existing bionic hands are already good substitutes for the natural limb yet a number of limitations prevail.
1 May 2013
Women’s Empowerment in Kenya
Fuel briquette technology is a promising alternative source of energy that could address unmet needs for cooking fuel, and create a number of socio-economic opportunities for women and low-income earners in Kenya.
1 May 2013
Getting Everyone On Board To Get Women On The Board
Gender equality in both the workplace and the home can only be reached if mindsets change in parallel with the creation of new laws, and codes of practice.
1 May 2013
The World Needs Science and Science Needs Women
With research showing that a mere 32 per cent of employed scientists and engineers are women, the challenge lies in being able to retain female scientific talent and encouraging a higher level of participation beyond school and into the workplace.
1 May 2013
Cancer: A Global Issue
While remains a widespread view that cancer only affects those in wealthier regions of the world and the elderly, at least half of cancers are diagnosed today in developing countries and these carry the greatest burden of premature mortality from cancer.
1 May 2013
The Ageing Heart
Research based at Imperial College in the area of Popeye domain containing aims to provide a novel insight into the ageing process and potentially provide new therapeutic opportunities to help the ageing heart.
1 May 2013
Ageing Societies
Better co-ordinating care, improving the flow of patient information and ensuring that adequate funding mechanisms are in place are crucial if societies are to deal with the challenges posed by ageing societies.
1 May 2013
Sexual Harassment in the Workplace
The past half century has seen leaps in women’s working rights, yet statistics show that sexual harassment is still a pervasive threat in the workplace.
1 May 2013
What Do Menstruating Girls Need in Schools?
Imagine trying to attend classes in these schools while you have your menstrual period. Imagine your menstrual period is extremely painful. Imagine your reuse-able pad is soaked through but there is no running water to clean it, or that there is no trash bin to get rid of it. And don’t forget this happens every month.
1 January 2013
Geo-Science Versus the Nuclear Industry
The Japanese government and their domestic nuclear industry are facing a serious dilemma. While geologists caution about the risk of active seismic faults the electric power industry is pressing the need to restart nuclear power plants.
1 January 2013
Investing in Africa
According to the International Monetary Fund, seven of the ten fastest growing economies over the next five years will be in Africa, a figure which is starting to capture the attention of both private and institutional investors.
1 January 2013
The BRICS
Since their emergence as a group, many commentators have championed the BRICS as good news for global health. However, this article seeks to explore whether it is right to assume that their economic accolades readily extend to the sphere of Global Health.
1 January 2013
Learning From Nature
It is possible to conceive of a complete bio-inspired security system concept which is likely to be radically different from more conventional approaches.
1 January 2013
Can We Make Our Demand for Food Sustainable and Secure?
Addressing over-consumption and waste are routes to reducing demand, but these probably won’t balance the need to produce more food. To what extent can we increase food production in a way that is both sustainable and secure?
1 January 2013
China’s Pro-Renewable Energy Approach
This article identifies the broad spectrum of challenges facing China’s energy sector and looks at the impact of this policy intervention on its development.
1 January 2013
How to Plan a Successful Biopharma Product Rollout
Effectively launching a new biopharma product, however, has never been more challenging. In addition to a litany of regulatory issues, companies face high stakeholder expectations, numerous market-access hurdles, and stiff competition, all of which are made more formidable by the business realities of the industry.
1 October 2012
Nanotechnology for Sustainable Development
The science of the very small, nanotechnology could play a key role in tackling many sustainable development issues ranging from fresh water supply and food decontamination to green technology.
1 October 2012
Spending the Money Wisely
All the heroic ambitions for improving global health must confront the prosaic reality of finding the necessary financial resources.
1 October 2012
Multi Drug-Resistant Tuberculosis
This article examines why drug resistant TB has come into existence, how it can be categorized, what treatment options are available and how the global health community plans to combat this growing threat.
1 October 2012
The Age of Minor Metals
Recent friction in the field of rare earths and platinum group metals demonstrate that it will be essential to find a mutually beneficial outcome for the mineral wealthy and the technology rich.
1 October 2012
On the Benefits of Competition in Healthcare
Governments faced with rising costs and growing demand are constantly searching for methods of delivering better healthcare. Reforms which promote competition are currently very much in vogue, yet while the political appeal is simple critics argue that the features of healthcare make the use of competition inappropriate.
1 October 2012
Mental Health and the Military
Never far from the media spotlight has been the mental health of those presently serving in the armed forces, those who have served (veterans), as well as the wider military community.
1 October 2012
Sunny Side Up: Photovoltaics of the Future
Until now only a fraction of 1% of energy has been provided by direct conversion of solar energy, but that is set to change: International Energy Agency projections anticipate that some 11% of electric power will be provided by solar technologies by 2050.
1 October 2012
Burying Our Nuclear Legacy
Geological disposal appears to be the best available approach to long-term nuclear waste management in the UK.
1 October 2012
Re-Thinking Rural Architecture in Syria
This article outlines a model for developing rural housing in Syria by means of relying on local resources including labour, materials and techniques.
1 October 2012
Preventing State Conflict in Cyberspace
Can a normative solution to state-sponsored cyber attacks bring peace to cyberspace?
1 October 2012
Antibiotics in Decline
The majority of antibiotic use is in the community, however the impact of antibiotic resistance is felt most acutely when treating patients in healthcare settings.
1 October 2012
Why Our Nuclear Waste Isn't Going Anywhere
The answer to nuclear waste disposal may lie in deep underground geological storage, yet this strategy faces strong ‘Not In My Back Yard’ opposition.
1 May 2012
China’s Digital Generations
While China is a huge online market, it is not an easy one. Although consumers are rapidly gaining sophistication, they have their own patterns of online consumption and behaviour that are different from those of consumers in the West.
1 May 2012
Lighting up Lives with Energy Efficient Lighting
New Light Emitting Diode (LED) technology could potentially achieve a reduction of 15% in total electricity consumption in developed countries
1 May 2012
Arsenic: Mass Poisoning in the 21st Century
Access to clean water is a fundamental human need. We must find low-cost ways of analysing toxic contaminants in the field, and develop cheap and effective remediation methods.
1 May 2012
Global Mental Health
For global health to truly deliver the overarching aim of health equality for all, it must overcome the artificial dualism separating mental from physical illness
1 May 2012
Healthcare in the Sahrawi Refugee Camps
In 1976 the Sahrawi people, fleeing Moroccan occupation of their neighbouring home nation of Western Sahara, were forced to settle in refugee camps in Tindouf, Algeria. Now, more than 35 years since the first settlements were formed, these temporary camps have evolved into a functioning society. However, the harsh desert environment has forced the camps to rely almost exclusively on international humanitarian assistance for their survival.
The Sahrawi people have had to build a health care system for themselves out of the bare, dry, desert. How did they do it? And what are the major challenges they continue to face?
1 May 2012
Mathematics and Statistics in Finance
Mathematical models for finance evolved radically from about 1900, when Bachelier applied Brownian motion as an underlying process to derive option prices.
1 May 2012
The Politics of Expanding Control of NTDs
Identified as a high impact, cost-effective and deliverable intervention, tackling NTDs through mass drug distribution has recently soared on the aid and development agenda
1 May 2012
Accra Invaded
High rates of urbanisation and population growth has led to housing and infrastructural incapacity in Ghana, threatening the country's economic success story.
1 January 2012